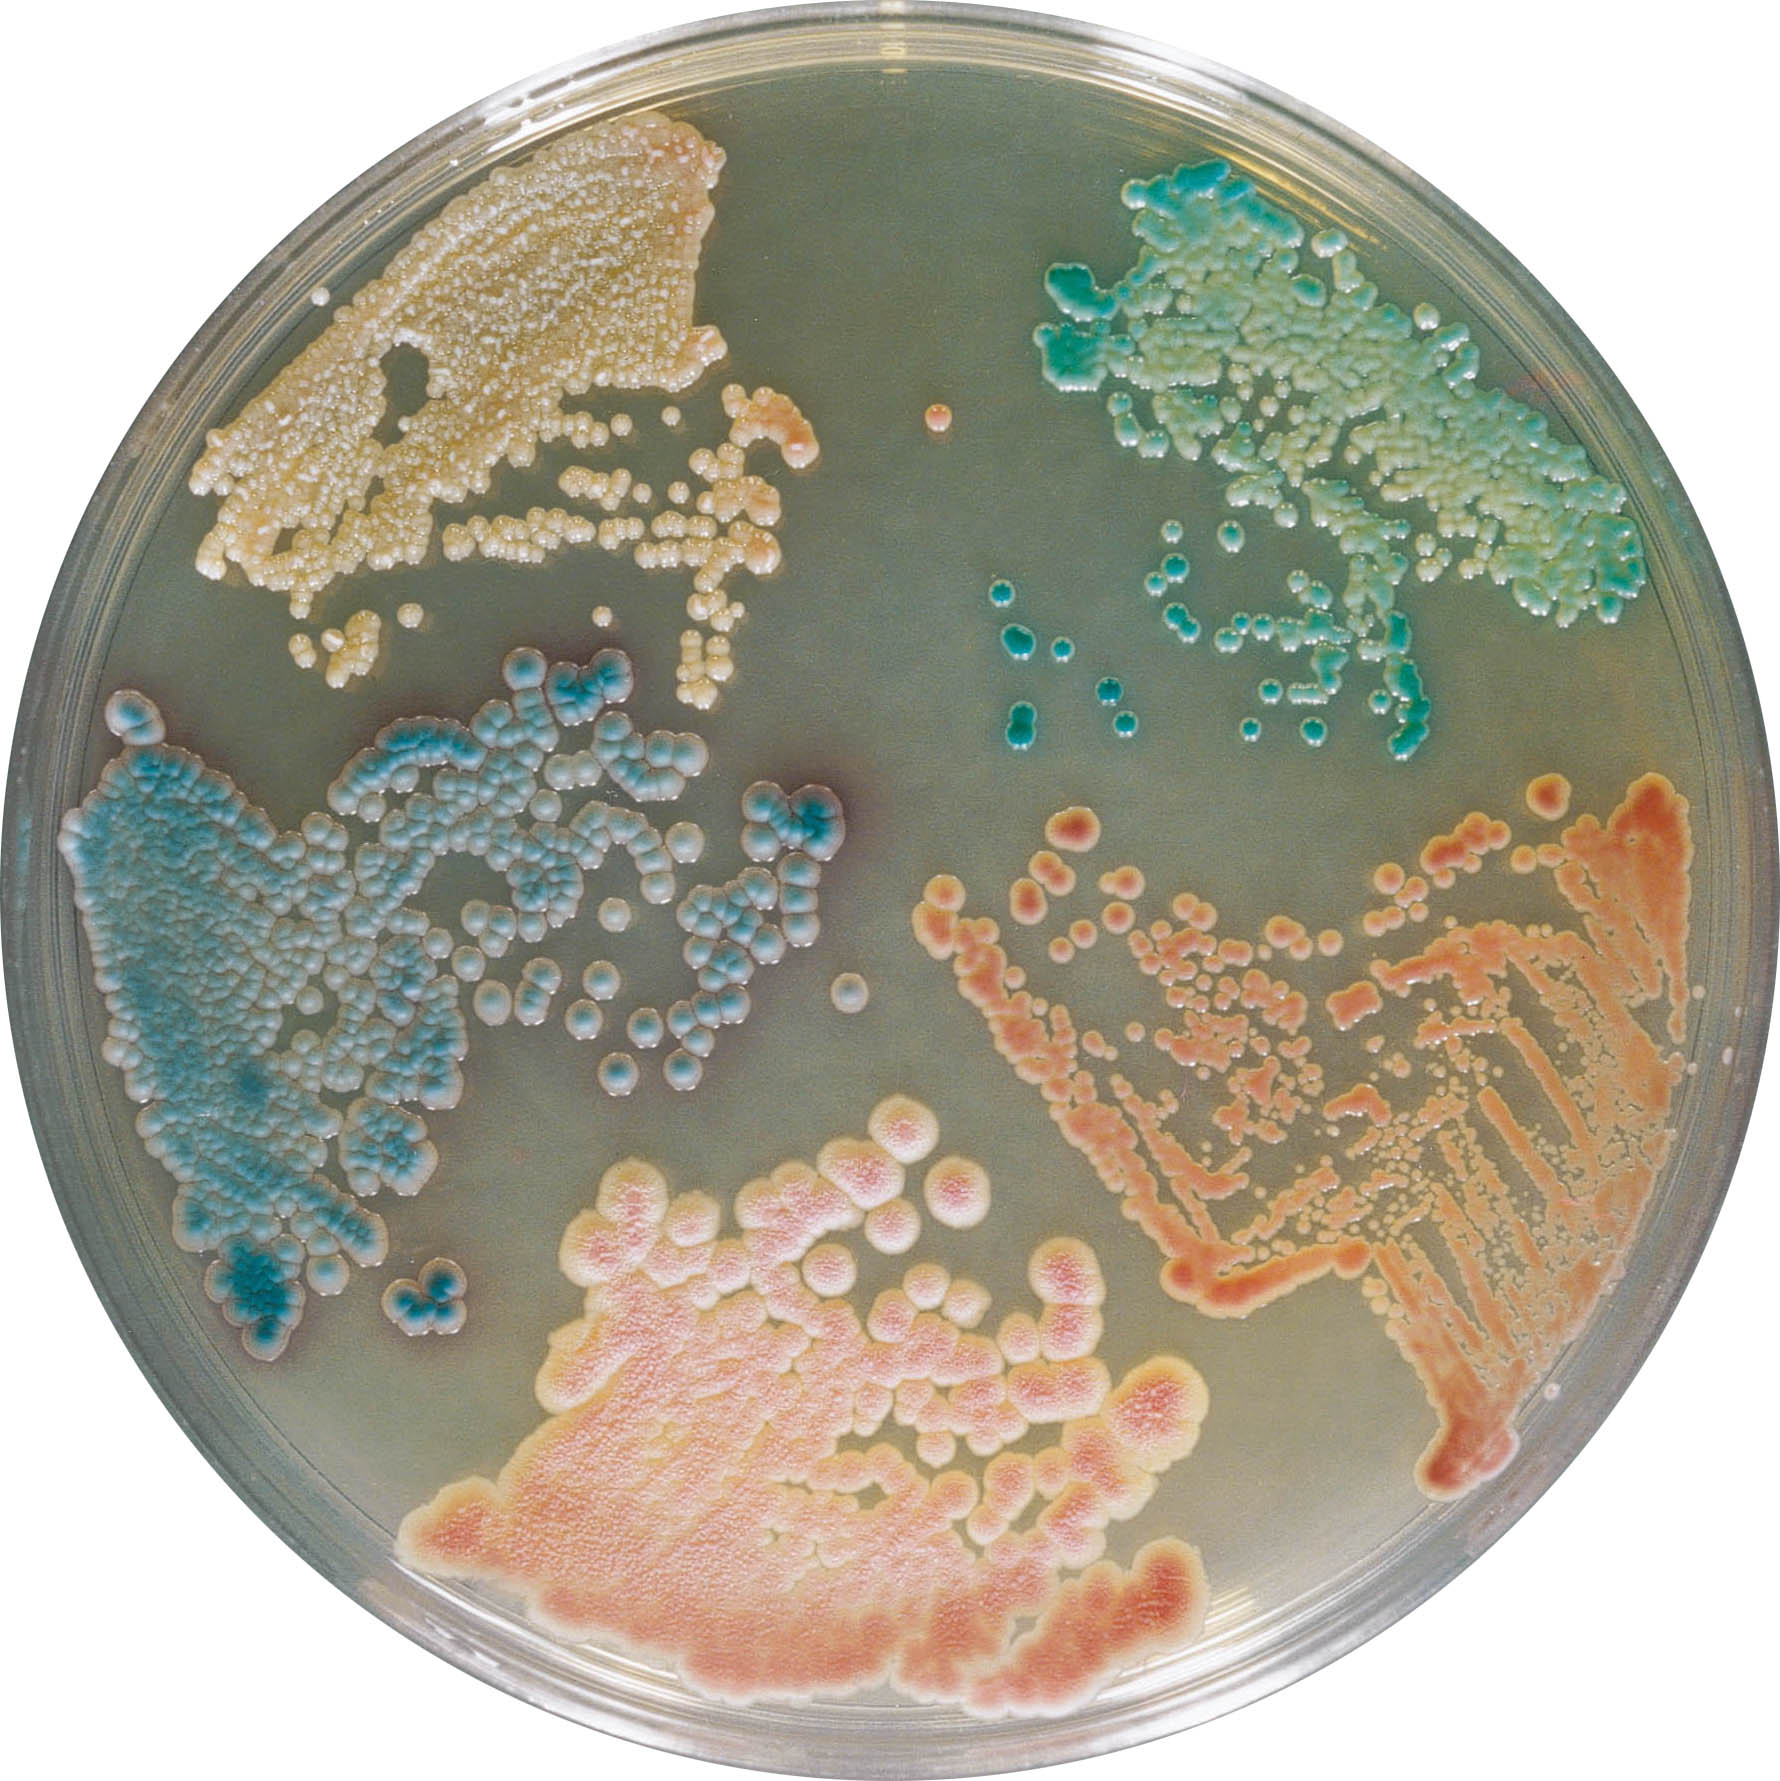
Sanimed -mTM CHROM Candida/Хромогенне середовище для виділення та диференціювання Candida spp.

24930000-2 Фотохімікати
Назва категорії: Живильні середовищаОдиниці виміру: штука
Технічні характеристики
Вид
Відповідність ДСТУ EN ISO 11133:2014
Фасування
Основа складу
Знайдено: 253

Пептон з казеїну (триптон), 500 г

Триптон соєвий агар (ТСA), 500 г

Хромогенне середовище для виявлення і диференціації Streptococcus A (S. pyogenes) / CHROM STREP A, Sanimed-M

Пептон бактеріологічний / PEPTONE BACTERIOLOGICAL,Sanimed-M

Ентерокок Агар / ENTEROCOCCUS AGAR, Sanimed-M

Поживний агар для визначення мікробного числа / PLATE COUNT AGAR / пласт. флакон 250 гр.

Агар Вільсона - Блера / WILSON-BLAIR AGAR, Sanimed-M

Агар діамантовий зелений
Sanimed -mTM CHROM Candida/Хромогенне середовище для виділення та диференціювання Candida spp.

Агар ксилозо-лизиновий дезоксихолатний

Бульйон з аргініном для аналізу декарбоксилації / DECARBOXYLASE BROTH WITH ARGININE, Sanimed-M
